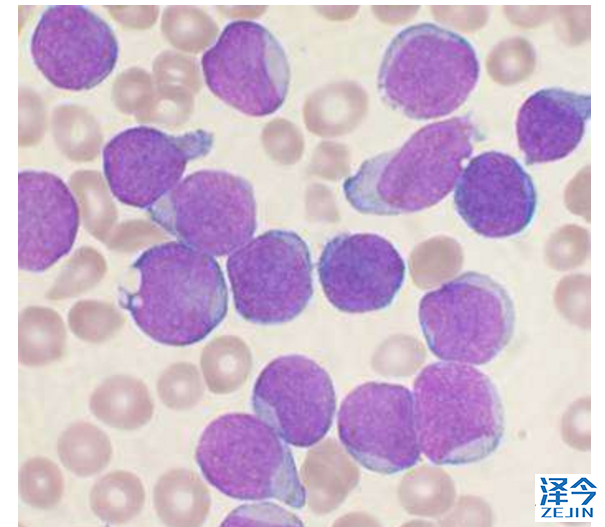

靶向药降价通知:上海泽今健康提供泰瑞沙(AZD9291),
乐伐替尼(仑伐替尼,E7080,Lenvima),哌柏西利,卡博替尼等靶向药物信息资讯,价格以药厂或医院即时通知为准 (通常以下调为主)现碧康公司主要产品均有下调,具体请咨询健康顾问17521780360,400-100-3607
。
生命不息,抗癌不止!近期也没有什么小长假了,你是否已经从慵懒的节假日中解放出来,步入正常的工作轨道及抗癌斗争中!小编已经完全进入到战斗状态,为各位癌友、癌友家属、医务人员等搜罗全球最新抗癌研究与进展,或许今天就有你需要的知识呢?跟Vicki一起来看看吧!
1、世纪之争终于尘埃落定!科学家首次发现儿童白血病诱因
最新研究首次揭示了儿童白血病可能的原因,这是一个经历了一个多世纪的争议。急性淋巴细胞白血病在当今社会特别普遍,发病率每年约增加1%。
伦敦癌症研究所的Mel Greaves教授评估了有史以来收集的急性淋巴细胞白血病(ALL)最全面的证据。得出结论,这种疾病是由基因突变和接触感染两个步骤引起的,这意味着在婴儿期可以通过治疗来刺激或激活免疫系统。
第一步涉及胎儿出生前发生的基因突变,并使儿童易患白血病,但只有1%的患有此遗传改变的儿童会继发为白血病。第二步也很重要。这种疾病后来在儿童时期通过接触一种或多种常见感染而被触发,在一岁之内没有任何异常发生,而与其他婴儿或较年长的儿童没有太多区别。
Greaves教授质疑过去有关可能的环境原因的报道,如电离辐射、电缆、电磁波或人造化学物质,因为没有强有力的证据支持这些是主要原因。相反,他提出了强烈的证据来证明ALL病因的“延迟感染”理论,其中早期感染有利于激活免疫系统,但是没有早期激活免疫系统的情况下感染可能引发白血病。
如果婴儿在一岁之内免疫系统被适当地激活,儿童白血病、I型糖尿病、其他自身免疫疾病和过敏等可能都是可以预防的,使儿童免受创伤和化疗的终身影响。
我希望这项研究将对儿童的生活产生真正的影响,或许可以通过简单安全的干预措施将婴儿暴露于各种常见和无害的免疫原中激活免疫系统,未来儿童白血病可能成为可预防的疾病。
2、柑橘皮作用大!对症头颈癌放疗后口干
根据斯坦福大学医学院的一项新研究,在柑橘油中发现的一种化合物可能有助于缓解头颈癌患者因放射治疗引起的口干症状。柑橘皮的油胞中含丰富的香精油,约为果皮鲜重的0.5%~2%。柑橘香精油的主要成分是d一柠檬烯(d-Limonene),对放射性口干起主要作用的就是d-柠檬烯这个化合物。
这种名为d-柠檬烯的化合物可以保护暴露于放射线治疗的小鼠唾液细胞,而不会削弱放射线对肿瘤的作用。Julie Saiki领导的研究人员也表明,口服d-柠檬烯可被运送到人体的唾液腺。用暴露于辐射的小鼠细胞进行的一系列实验表明,d-柠檬烯降低了成人和唾液干细胞和祖细胞中的醛浓度。即使在辐射暴露后数周处理细胞时,d-柠檬烯仍能改善其恢复能力,修复腺体结构并产生唾液。接受d-柠檬烯并暴露于辐射的小鼠也比没有接受d-柠檬烯并暴露于辐射的小鼠产生更多的唾液。
接受放射治疗的头颈癌患者中约有40%患有口干症,这不仅令人不舒服,还会使患者难以说话和吞咽,而且更容易患上口腔疼痛或蛀牙,并且在某些情况下可导致牙齿脱落。而且,虽然治疗后的头几年可能会出现一些恢复,但一旦唾液产生功能受损,通常会终身受影响。后续的研究还在进行,如果它能够起作用,那么这种药物将被安全地用于长期防止患者口干,并且使患者在治疗后耐受放射治疗并提高生活质量变得更容易。
3、昨日FDA批准血小板减少症新药
昨日,Dova Pharmaceuticals宣布美国FDA批准其子公司AkaRx的新药Doptelet(avatrombopag)片剂用于治疗计划接受医疗或牙科手术的慢性肝病(CLD)成人患者的低血小板计数(血小板减少症)。值得一提的是,这是FDA在一周内批准的第三款新药,也是目前获批用于该用途的首款药物。
血小板是骨髓中产生的无色细胞,帮助在血管中形成血凝块,防止出血。癌症化疗通常会引起血小板减少。
Doptelet(avatrombopag)是第二代、每日一次的口服首个血小板生成素(TPO)受体激动剂。Doptelet能模拟TPO的作用,它是正常血小板生产的主要调节者。该药物曾获得优先审评资格,治疗将接受手术的CLD成人患者的血小板减少症。
Doptelet的安全性和有效性在两项试验(ADAPT-1和ADAPT-2)中得到了验证。这些研究共包含435名慢性肝病和严重血小板减少症患者,他们将接受通常需要输注血小板的手术。这些试验评估了两个剂量水平的口服Doptelet与安慰剂相比治疗5天的效果。结果显示,与安慰剂组相比,两种剂量水平的Doptelet组有较高比例的患者具有增加的血小板计数,并且不需要在手术当天和治疗后7天内接受血小板输注或任何救援治疗。Doptelet最常见的副作用有发烧、胃(腹)痛、恶心、头痛、疲劳和手足肿胀(水肿)。
“具有低血小板计数和需要手术的慢性肝病患者的出血风险增加,”FDA药物评估与研究中心肿瘤学卓越中心主任兼血液学和肿瘤学产品办公室代理主任Richard Pazdur博士说:“Doptelet被证明可以安全地增加血小板计数。这种药物可能会减少或消除对血小板输注的需求,(血小板输注)可能增加感染和其它不良反应的风险。
4、血癌药物对致命性三阴乳腺癌有效??
Mayo Clinic最近一项研究发现,FDA批准用于治疗骨髓增生异常综合征的药物可能有助于治疗三阴乳腺癌,这是最具侵袭性和致命性的乳腺癌之一。
研究人员发现FDA批准用于治疗某些血液癌症的药物5-氮杂-2'-脱氧胞苷(地西他滨)可以显着抑制三阴乳腺癌的生长,并且重要的是在对化疗耐药的肿瘤中也可见到这种效应。Mayo研究员Liewei Wang博士说:“非常需要为三阴乳腺癌确定更多的治疗方案,这是最难治疗的乳腺癌亚型之一。这项研究证明我们可以利用现有的许多FDA批准的药物,了解其机制来扩大其他癌症的使用范围。”
研究从用化疗治疗的乳腺癌患者产生患者衍生的异种移植物(永生化乳房肿瘤细胞)。在来自BEAUTY的活体异种移植物中发现,当存在DNA甲基转移酶蛋白质时,地西他滨在低负荷治疗剂量下对三阴性乳腺癌有效。低剂量会导致较低的毒性,并可能使药物使用更长时间,所有这些都可能有助于实现更好的治疗效果。
Goetz博士表示,正在计划研究地西他滨在一项名为BEAUTY2的前瞻性临床试验中的影响,该试验侧重于对化疗耐药的三阴性乳腺癌患者。
5、结直肠癌快速诊断高科技缩短检查时间160倍
鲁尔大学研究人员利用量子级联激光器部署了一种新型红外(IR)显微镜,以分析在常规临床过程中用于结直肠癌诊断的组织样品。目前使用的傅立叶变换红外(FTIR)显微镜尚未在医院中作为诊断工具,因为分析时间过长。通过使用新型激光技术,研究人员将分析所需的时间从一天缩短到几分钟。再加上生物信息图像分析,红外显微镜可执行无来源标记的癌症组织分类,并且可以完全自动化。
与传统的临床快速诊断测试(大约需要20分钟)不同,FTIR成像过去需要一整天的时间。现在,研究人员已经大大简化了测量设置,并用量子级联激光技术取代了FT技术,类似于用精确捆绑的强激光替代发出漫射光的弱光灯泡。使用红外成像技术分析了120例患有结直肠癌患者的组织标本,结果与传统的组织病理学分析结果相当,一致性达97%,同时将测量周期缩短了160倍。
将来,该团队打算将该方法纳入临床工作流程。自动图像分析可能作为一种节省时间的诊断工具应用于临床。结直肠癌是最常见的癌症之一,早期诊断预后很好。这项研究的结果带来了希望,高度精确的治疗是可以实现的,可以为每个病人个性化治疗。
6、癌细胞中的基因突变可预测药物治疗效果
如今,可以对抗癌症的疗法其实不在少数,然而,在治疗过程中,很多患者会因为治疗反应不佳而延误了真正有效治疗的黄金时间。来自kaist的研究小组开发了寻找特定类型癌细胞的最佳药物靶标。研究小组使用系统生物学分析分子网络动力学,通过癌细胞中的基因突变预测药物响应。
该技术大大促进未来抗癌药物的开发,在癌细胞中有许多类型的遗传变异,包括基因突变和拷贝数变异。这些变化在癌细胞中是不同的,即使在相同类型的癌症中也不尽相同,因此,药物响应会根据细胞的变化而变化。癌症研究人员致力于识别癌症患者频繁发生的遗传变化,特别是可用作特定药物指标的突变。
以前的研究集中于鉴定单个基因突变或对基因网络的结构特征进行分析。然而,这种方法的局限性在于不能解释癌细胞中由基因和蛋白质相互作用诱导的癌症生物学特性,这导致药物应答的差异。癌细胞中的基因突变改变了这些基因和与其蛋白质相互作用的基因的功能。因此,一个突变可能导致分子网络的动力学性质的改变。因此,癌细胞对抗癌药物的反应不同。
新一技术的发展,可以通过预测药物响应,为不同类型癌细胞找到最佳药物目标。该技术应用于已知的抑癌基因p53的分子网络。研究人员说:“癌细胞中的基因变异是引起不同药物反应的原因,但是还没有进行完整的分析,系统生物学可以模拟癌细胞分子网络的药物反应,从而使用新的概念方法确定药物反应的基本原则和最佳药物靶点。”
https://medicalxpress.com/news/2018-05-uk-scientist-reveals-childhood-leukaemia.html
https://medicalxpress.com/news/2018-05-compound-citrus-oil-mouth-neck.html
https://www.fda.gov/NewsEvents/Newsroom/PressAnnouncements/ucm608320.htm
https://medicalxpress.com/news/2018-05-potential-treatment-option-triple-negative.html
https://medicalxpress.com/news/2018-05-label-free-method-rapid-cancer-diagnosis.html
https://medicalxpress.com/news/2017-12-team-technology-optimum-drug-cancer.html
声明:
本公众号内容仅作交流参考,不作为诊断及医疗依据,仅依照本文而做出的行为造成的一切后果,由行为人自行承担责任。专业医学问题请咨询专业人士或专业医疗机构。